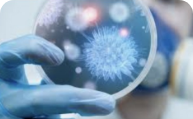

A five-year retrospective review on 1357 positive fungal nail culture in Hospital Kuala Lumpur (HKL) (2011-2015).
The study showed that non-dermatophyte were predominant fungi isolated from diseased nails in their cohort followed by yeast and dermatophyte.